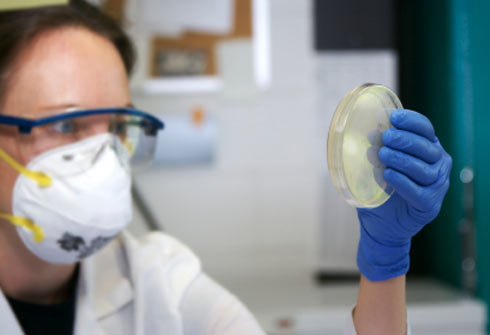

Medindia » Multimedia » Slideshows » Bioterrorism

Symptoms: Increase in body temperature, tiredness, cough and congestion followed by difficulty in breathing. Victims may also sweat excessively, while some may turn blue, medically termed as cyanosis.
Vaccine: The vaccine will be effective only if it was given one and a half years prior to exposure.
The Infliction (Threat): Contact with infected animals, eating contaminated meat or inhaling contaminated spores can cause the spread of infection.
Anthrax spores can survive in the ground or in water for years together and can easily be dispersed in the air by missiles, rockets, aerial bombs and sprayers. Only a few spores are required to cause the infection. Infection: Death occurs within 24-36 hours after onset of symptoms.
Symptoms: Fever, chills, headache, difficulty in breathing and blood in sputum are some of the common symptoms. Symptoms of plague usually sets in 1-6 days after exposure.
Vaccine: There is a vaccine to prevent bubonic plague. Aerosolized plague can be treated with antibiotics, and if given immediately, greatly improves the chances of survival. Threat: Bubonic plague is transmitted to man through fleas that have fed on the blood of an infected rat. Aerosolized plague is more dangerous and death can occur within a few days. Infection: Death occurs within 2 or 4 days after the onset of symptoms.
Symptoms: Symptoms show up in about 10-12 days after exposure. Some of the initial symptoms are fever, tiredness and back pain. Two or three days after the initial symptoms, victims suffer rashes and pustules on the face, arms and legs.
Vaccine: Smallpox was eradicated sometime in 1972, yet we still have about 15 million doses available in the US and Russia. Threat: Smallpox can prove fatal as it is highly contagious and spreads quickly. Though it has been eradicated, smallpox can be a potential biological weapon. Infection: About 35% of patients die within the first two weeks of the onset of symptoms.
Symptoms: Usually appear 12-36 hours after consumption of spoilt food. Symptoms include blurred vision, slurred speech, difficulty in swallowing, general weakness.
Vaccine: The anti toxin must be administered as soon as possible. The Inflict: Botulism is caused by a toxin botulinum which can be extremely powerful. It can be used to infect water and food supplies, though the latter is more safe as chlorine destroys the pathogen. It is not contagious and is unlikely to be used as a biological reaction as it is difficult for dispersal. Infection: Victims who take in small amounts may survive but larger doses can cause breathing problems and death within a short time.
Symptoms: Fevers, muscle pain, chills and diarrhea begin within few days followed by severe angina, shock and bleeding.
Vaccine: There are no vaccines for hemorrhagic fever. Yellow fever does have a vaccine.
Threat: Hemorrhagic Fever is caused by a different group of viruses- arenaviruses, bunyaviruses, flaviviruses and filoviruses. Strains are available only in a few laboratories in the world.
There are technical obstructions in dissemination of these as biological weapons. Only the Ebola form of the virus is deadly if made air borne and inhaled. Infection: The disease is not always fatal but Ebola virus results in death in 90% of the cases, within a week following the infection. MEDINDIA
MEDINDIA